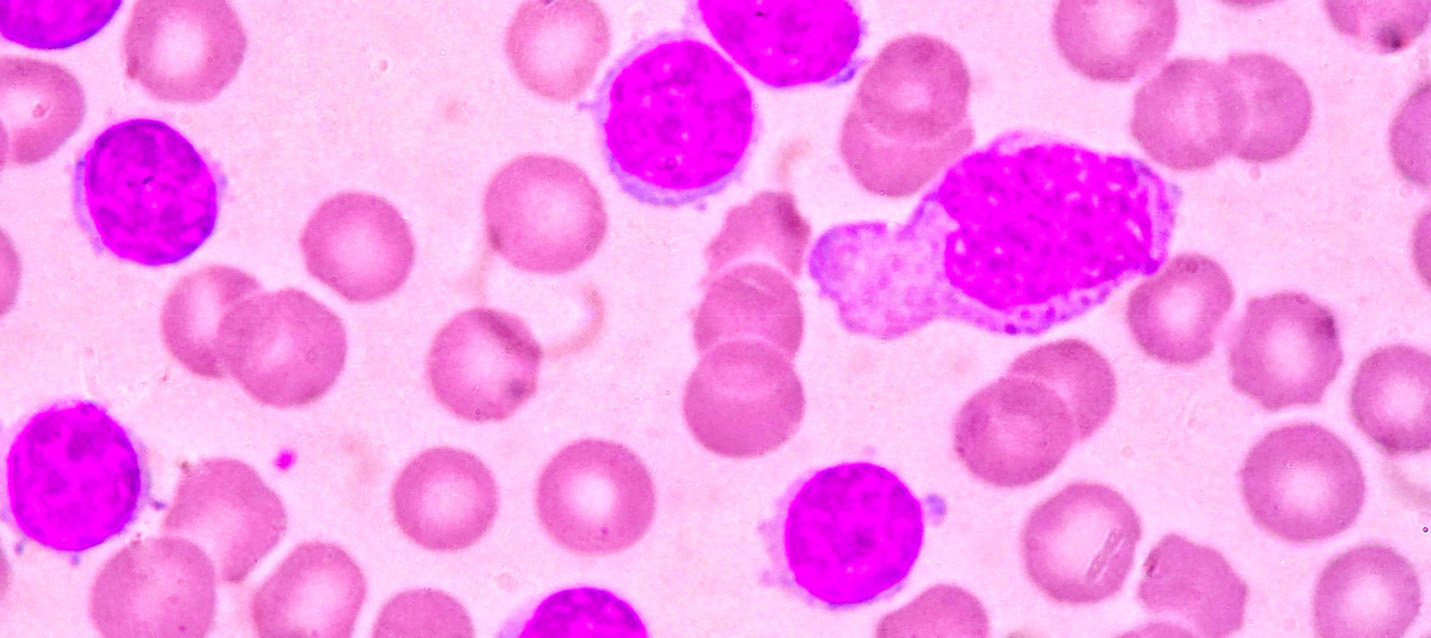

The Perfect Gene Diet foreword, written by Dr. Wayne Dyer

Below, I share the foreword from my book, The Perfect Gene Diet, written by Dr. Wayne Dyer, who was an internationally renowned author and speaker in the fields of self-development and spiritual growth.
“The book you now hold in your hands can and will not only change your life for the better, but if you read and apply it seriously, it will very likely save you from an unnecessarily early demise. This is quite a claim, and the reason I can speak from such an authoritative position is because that is precisely what it has done for me.
I have heard it said that a coincidence is nothing more than God hiding behind a cloud and smiling. Well, the day that Pam McDonald came into my life, God was not only smiling behind that cloud, but I’m certain that he was winking and clapping for having arranged such a fortuitous meeting.
Pam and one of her colleagues had come to Maui to meet with me and share some of the enormous successes they’d had in treating patients with serious disease via the new integrative- medical science, in combination with the teachings I’ve been speaking about publicly for the past 35 or so years. They didn’t know exactly where I lived, so they both followed their intuitive knowing and simply waited in the grassy area near the beach in west Maui where I live part-time. On the day we met, I had just returned from a visit to a medical team and had been informed that I was living with a medical condition called Chronic Lymphocyte Leukemia (CLL). Someone or something smiling from behind the cloud urged me to go outside and take a walk on a path that I had never taken before at a time when I had never exercised before. As I walked—my mind in a quandary as I attempted to grasp what I’d just heard a few hours before—I was approached by Pam and her colleague Kim. They asked if I could take a few moments to share the excitement they felt concerning their work and how my own life’s work had been so instrumental to them in applied integrative medicine.
My mind at that moment was not open to talking to anyone about anything, since I was somewhat in shock about what I had just learned. All I really wanted to do is go for a long walk alone and meditate and ask for Divine guidance as to what my next step should be. As I have said so often, in times of need, God can come to you in a myriad of disguises, so have a mind that is open to everything and attached to nothing.

After talking politely for a few moments, I simply blurted out what I’d just learned about the leukemia diagnosis, and Pam said to me without hesitation, “I thought I came here to share our findings in integrative medicine and the APOE Gene diet, but obviously I was sent here to help you heal your own body.” Since that day, Pam McDonald, the author of this life-changing—no, lifesaving, book—has been my constant integrative-medicine practitioner and has personally guided me to a whole new level of mind/body health.
This book is loaded to the gills with specific information that will indeed transform your life in so many ways. Basically, the book is well written and professionally researched in order to be of assistance to anyone embarking on a healing path. If this were not true, I would not be writing this Foreword and endorsing this material enthusiastically.
What the book doesn’t do, however, is tell you about the spiritual consciousness embedded in the author, who painstakingly researched and wrote this amazing material. Pam McDonald lives and breathes what she writes about. She immediately arranged to have my blood tested and discovered that I was a 3/3 on the Apo E gene scale. She designed a specific diet for me, taking
into account the fact that the test revealed I had one of the highest cholesterol traits predictive of aggressive heart disease she had ever seen—even thought my routine-screening cholesterol test showed me to be in the normal range. She further noted that based upon my genetic coding, the medications I was taking were completely wrong for my genetic trait.
Pam took it upon herself to prescribe the correct treatment, along with dietary recommendations that would serve to reduce my cellular inflammation and put me back on to a regimen of well-being in harmony with my own genetic blueprint. As a 3/3, the worst thing I could do was go on a low-fat diet. Indeed, I learned that my body could not process and break down certain foods that I had been eating for a lifetime. It was Pam who arranged to have my blood properly processed. And she was also the one who called me every day to ensure that I understood which foods I had to avoid and which ones I needed to make the major focus of my new eating regimen.
It was Pam who met with me in San Diego to reinforce the essential connections between the kinds of food I was eating and my ability to live out my life from a place of well-being, balanced with my own genetic traits. It is still Pam who sends me messages and updates on a regular basis to remind me to stay on the path of the Perfect Gene Diet, which, by the way, is simple and easy and in no way a sacrifice or a hardship. It is the love and higher consciousness in these remarkable women who researched and wrote this book that I want to acquaint you with here in these moments before you immerse yourself in this information.

This is not a book with a radical new diet for you to experiment with as you lose those extra pounds. Rather, it is an approach that, with a simple test, will evaluate your individual genetic map and then provide you with the correct do’s and don’ts—nutritionally, physically, and spiritually—to keep you balanced with respect to the DNA model that was handed to you at birth.
Pam McDonald is not just an integrative-medicine practitioner, but she embodies the idea that when people with serious chronic conditions such as heart disease, Alzheimer’s, leukemia, diabetes, and so on become aware, they need not stay stuck in the progressive deterioration that accompanies these chronic illnesses. Their symptoms can and will begin to disappear, and they’ll start to look and feel better.
Since I have been on the Perfect Gene Diet, I have managed to improve my white blood count; take off 18 excess pounds without even feeling like I’m dieting; enhance my lung capacity; increase my energy; and, more important, simply feel better each and every day. And Pam McDonald has gone from being a stranger who had used my materials in concert with her work and who wanted to share it with me, to being the single most significant person—medical or otherwise—who has helped me get and stay on a dietary regimen perfectly compatible with what God had in mind when he brought this body of mine into this physical world from the infinite, formless world of Spirit.

I personally took this book to my publisher and made the case to Hay House to bring this message to the masses. This has been publisher Louise Hay’s mission for as long as I known her, and when I told Hay House of my strong feelings about this, along with the integrity and commitment of its author to making this shift toward an integrative-medicine approach, my publisher jumped on board and elected to bring it to you. I am so proud to write these few supportive words in the opening pages of this monumental work, and I endorse the Perfect Gene Program wholeheartedly. I also endorse the author, and I especially want to thank God for urging me to go out into the world on that day of my own diagnosis and meet the women who brought a sense of sanity back to my eating regimen, which allowed me to continue to help others as a result of the help that has been delivered to me.”
The book was launched on 10: 10: 10 in Maui, Hawaii